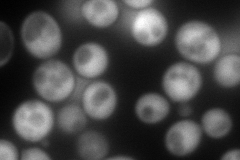
YLR270W
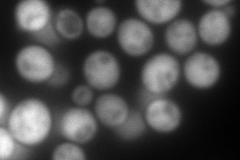
YLR270W
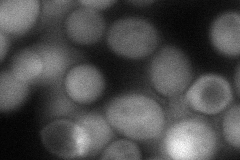
YLR270W
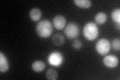
YLR270W

View description
Non-essential hydrolase involved in mRNA decapping, may function in a feedback mechanism to regulate deadenylation, contains pyrophosphatase activity and a HIT (histidine triad) motif; interacts with neutral trehalase Nth1p
Localization:
Intensity:
Fold change:
Significance:
-
C’ GFP library in SD

cytosol63.06 -
N' NOP1pr-GFP in SD
cytosol280.729 -
N' TEF2pr-mCherry in SD
cytosol369.85 -
N' NATIVEpr-GFP in SD

cytosol22.2457 -
N' TEF2pr-VC and Cyto-VN in SD
cytosol79.3912 -
C’ GFP library in SD+DTT

cytosol73.21.16No -
C’ GFP library in SD+H2O2

cytosol831.31No -
C’ GFP library in Starvation Media
cytosol178.052.82Yes -
C’ GFP library on the background of Pup2-DaMP

cytosol -
C’ GFP library on the background of CCT mutant

cytosol67.96121.07755No
